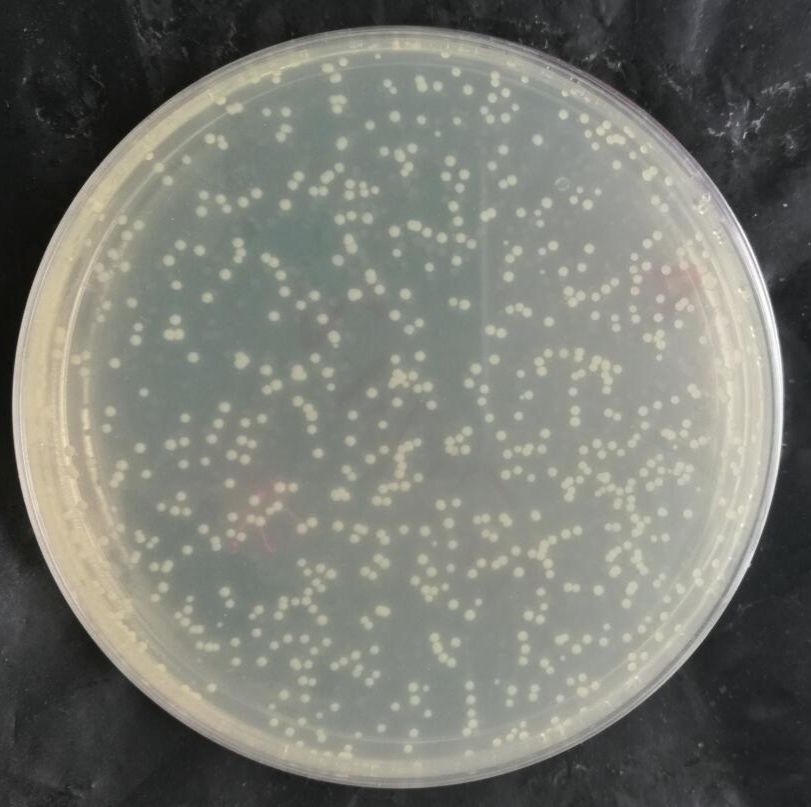
pENTR223-CARF-T1395G人源基因质粒

相关产品推荐更多 >
万千商家帮你免费找货
0 人在求购买到急需产品
- 详细信息
- 文献和实验
- 技术资料
- 库存:
100
- 保质期:
5年
- 供应商:
上海烜雅生物科技有限公司
- 保存条件:
-20℃
名称:pENTR223-CARF-T1395G人源基因质粒
别称: NM_024744.16ALS2CR8;NYD-SP24
复制子:pUC
原核抗性:Spe
克隆菌株:DH5a
培养条件:37度
质粒属性
载体宿主:大肠杆菌
载体用途:PCR模板
基因种属:人
基因类型:cDNA
原核抗性:Spe
真核抗性:
荧光蛋白:
质粒简介 : 祥询
质粒序列 :祥询
质粒菌株产品操作说明书
一、扩增流程
收到产品后,请先根据产品管壁标签来判断产品形式,并在扩增前准确查找该质粒菌株的抗性、感受态和培养温度。
1、质粒干粉(常温运输,存于-20度,90天保质期,请务必转化挑单克隆培养,不要直接使用和测序)
①收到质粒干粉后请先5000rpm离心1min,再加入20μl ddH2O去离子水溶解质粒;
②取1支100μl 感受态于冰上解冻10min,加入2μl质粒,再冰浴30min后,42℃热激60s,不要搅动,再冰浴2min;(从第二步开始均要在超净工作台中无菌操作)
③加入900μl无抗的LB液体培养基,180rpm震荡37℃培养45min;
④6000rpm离心5min,仅留100μl上清液重悬细菌沉淀,并涂布至目标质粒抗性的LB平板上;(可使用本平台的平板涂布专用玻璃珠进行涂布,可以比传统涂布方法获得更多转化子)
⑤将平板正向培养1h,再倒置37℃培养14h。如果要求是30度则培养20h;
(菌落过多则将质粒稀释后再转化。没有菌落则加入10μl质粒转化。另不要直接转表达感受态,要先转克隆感受态,重提质粒后再导入表达感受态)
⑥挑取单菌落至LB液体培养基中,加入对应抗生素,220rpm震荡培养14h,根据实验需要和质粒提取试剂盒说明书提取质粒。
2、甘油菌种(冰袋运输,存于-80℃,保质期90天,请务必划线挑单克隆培养)
四区划线后挑单菌落培养,酵母菌需要先液体复苏再四区划线,再挑单菌落液体培养。
3、穿刺菌种(冰袋运输,存于4℃,保质期7天)
穿刺接种,液体培养后四区划线,再挑单菌落液体培养。
4、菌落平板(冰袋运输,存于4℃,保质期7天)
直接挑取单菌落至液体培养基中。
5、液体质粒(冰袋运输,存于-20℃,保质期90天)
单独提取的液体质粒收到后可直接使用。
6、滤纸质粒(常温运输,存于-20度,90天保质期,请务必转化挑单克隆培养,不要直接使用和测序)
收到货后将滤纸画圈部分剪下放入EP管中,加100ul无菌水将滤纸浸湿并浸泡5min,吸取5ul质粒转化,离心全涂。
二、转化图片
相关产品
| P4243/pCMV-SPORT6-UFSP2人源基因质粒 |
| P4244/pCMV-SPORT6-BPGM人源基因质粒 |
| P4245/pCMV-SPORT6-TRIM31(2同义突变1点突变)人源基因质粒 |
| P4246/pCMV-SPORT6-HTATIP2人源基因质粒 |
| P4247/pCMV-SPORT6-CALB2人源基因质粒 |
| P4248/pCMV-SPORT6-CARD14人源基因质粒 |
| P4249/pCMV-SPORT6-SLC17A5(1同义突变)人源基因质粒 |
| P4250/pCMV-SPORT6-TRMT1人源基因质粒 |
| P4251/pCMV-SPORT6-TMEM187人源基因质粒 |
| P4252/pCMV-SPORT6-TAF1B人源基因质粒 |
风险提示:丁香通仅作为第三方平台,为商家信息发布提供平台空间。用户咨询产品时请注意保护个人信息及财产安全,合理判断,谨慎选购商品,商家和用户对交易行为负责。对于医疗器械类产品,请先查证核实企业经营资质和医疗器械产品注册证情况。
文献和实验memoday 最近在做一个信号通路的下游磷酸化水平检测,但是做western没有看到任何条带,包括p-ERK,p85。麻烦各位战友帮我分析一下可能原因吧: 1.293T细胞转染质粒(带外源基因),24h 2.无血清培养18h 3.配体(外源基因是该配体的膜受体)激活,37度,10min 4.PLB(promega公司)裂解细胞,做western,抗体是SANTA CRUZ公司的p-ERK (Tyr 204),以及cell
酶活性;2. 10×CIP 缓冲液和 1U CIP,混合后,37 ℃ 孵育 30~60 min,然后 75 ℃ 加热 15 min 灭活 CIP 活性;3. 琼脂糖凝胶电泳分离并纯化目的 DNA 片段用于连接反应。(二)连接反应【实验试剂与器材】1. T4 DNA 连接酶2. 10×T4 连接酶缓冲液【实验方法与步骤】反应体系:质粒 DNA (0.5(g/? 滋 l) 2? 滋 lDNA 插入片段 (300ng/? 滋 l) 5? 滋 l10× 连接缓冲液 1? 滋 lT4 DNA 连接酶 1? 滋 l加水
这些引物.对所挑选的菌落中的质粒进行 PCR 扩增以鉴定是否有插入片段以及插入片段的大小.例如 T-A 克隆载体,克隆位点两侧有 T 7 、 SP 6 和 M 13 启动子通用序列,用 PCR 鉴定就非常方便.但是多数实验室更喜欢用酶切鉴定。 (二)插入片段方向性鉴定 如果需要 基因表达 ,必需鉴定外源基因在重组质粒中的连接方向.这对于在克隆时使用单酶切位点的情况尤为重要.可以利用联合酶切方案进行目的基因的插入方向鉴 定.在基因插入的邻近末端部位选择一个单酶切点( B